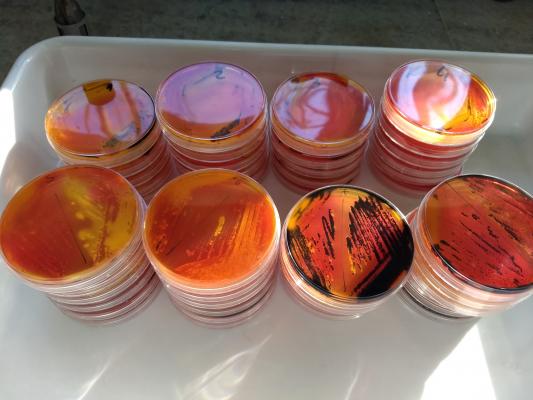

Evaluación oficial de vacunas de Salmonella para la avicultura
INTA, institución estatal para la generación de conocimiento en ciencia, investigación e innovación agropecuaria y agroindustrial, en conjunto con SENASA, organismo oficial puesto al servicio de la prevención y control de las enfermedades de los animales han construido un fuerte vínculo, consolidado desde hace muchos años.
En la temática avícola, a partir del año 2013 se inició la colaboración técnico-científica entre el equipo de trabajo del SENASA – liderado por María Victoria Terrera, jefa del Departamento de Aves de la DILAB-SENASA – y el grupo de trabajo “Salmonella y Campylobacter” del Instituto de Patobiología de INTA, cuyo responsable es Pablo Chacana.
El objetivo es la evaluación de la calidad de vacunas para uso en avicultura. Como producto de este relacionamiento y, ante la posibilidad de poder mejorar las capacidades del país para poder evaluar la calidad de inmunógenos de uso en avicultura, ambos equipos de trabajo han generado procedimientos estandarizados que permiten evaluar la inmunogenicidad, inocuidad y eficacia necesarias para el registro de vacunas destinadas al control de Salmonella, y estableciendo requisitos mínimos para su aprobación. El propósito final de estas acciones conjuntas es conocer y mejorar la calidad de los productos biológicos que se utilizan en el país para el control de este patógeno, uno de los más relevantes para la producción de aves debido a sus implicancias en la Salud Pública, la producción animal y el comercio internacional de productos avícolas.
De esta manera, y en el contexto de un Convenio de Cooperación Técnica suscripto por las autoridades de ambas instituciones en el año 2016, se han llevado a cabo distintos ensayos oficiales que involucran la vacunación de aves y la evaluación de distintos parámetros que permiten determinar su eficacia contra el patógeno.
Los ensayos son consensuados con los diferentes laboratorios que desean registrar su producto para ser comercializado y utilizado en el país. La ejecución técnica es llevada a cabo por el grupo de trabajo del INTA aprovechando su trayectoria y capacidades instaladas en esta temática. Por su parte el equipo de SENASA audita los ensayos y decide, en base a los resultados, si se han cumplimentado los requerimientos necesarios para su aprobación.
Bibiana Brihuega, directora del Instituto de Patobiología, reflexiona al respecto de la labor con SENASA “históricamente nuestro instituto se ha relacionado estrechamente con esta institución brindando soporte técnico, participando en mesas de discusión y entrenando a personal en distintas metodologías diagnósticas. Estamos muy orgullosos de poder mantener y fortalecer este trabajo conjunto que estamos seguros beneficia a ambas instituciones y potencia el trabajo de nuestros investigadores”.
Hasta la fecha, se han realizado ensayos para evaluar la inmunogenicidad de vacunas inactivadas de tipo bacterina y también se determinó la eficacia de vacunas vivas atenuadas y vacunas a subunidad pertenecientes a distintas empresas.
El relacionamiento entre los grupos, según Chacana, “ha resultado sumamente fructífero para ambos equipos de trabajo, ha favorecido el aprendizaje mutuo y fortaleció las capacidades de ambas instituciones”. Permitió también la generación de espacios de diálogo con el sector privado para lograr el objetivo común: aportar al mejoramiento de las herramientas destinadas al control de Salmonella en la avicultura argentina.
Chacana agrega: “Además de esta actividad, nuestro equipo de trabajo colabora activamente con otros programas del SENASA que tienen distintos objetivos, como por ejemplo la vigilancia de la resistencia a antimicrobianos en las producciones animales. También participamos de comisiones interdisciplinarias de sanidad animal para realizar nuestro aporte en la discusión y búsqueda de soluciones a problemáticas sanitarias del país. Por otro lado, tenemos un fuerte relacionamiento con distintas empresas a través de convenios de vinculación tecnológica para brindar asistencia técnica y generar nuevos productos para el control de Salmonella, actualmente estamos trabajando en el desarrollo de vacunas, entre otros”
Victoria Terrera afirmó “estamos muy satisfechos de haber podido generar esta interacción que nos ha permitido mejorar las capacidades para la evaluación de vacunas de Salmonella, que se encontraba vacante en nuestro país. Tenemos confianza que en el futuro seguiremos adelante con este tipo de ensayos y también con nuevos desafíos que llevaremos a cabo conjuntamente con el INTA”.
Fuente: INTA